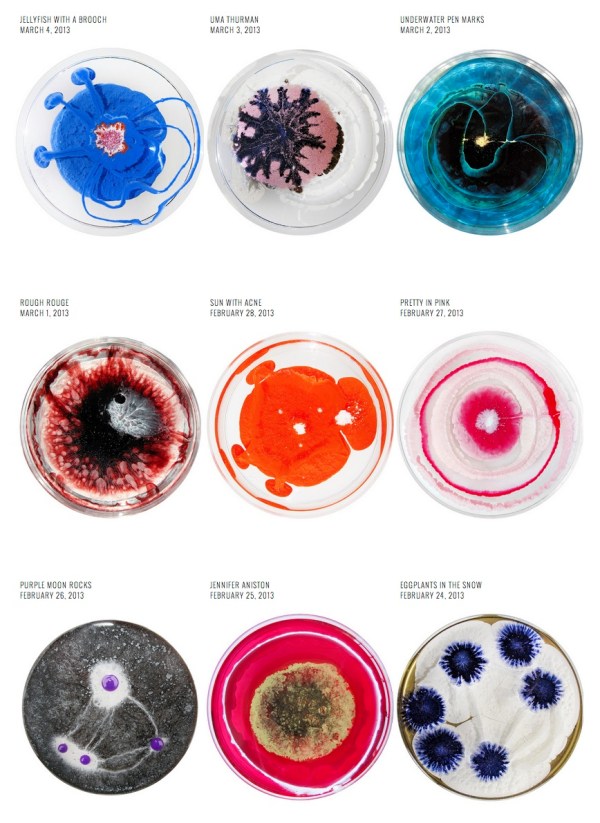
dailydish

Tag: microbiology
March 31, 2014
November 28, 2013
I guess it might look like this if microbes were to suit up like Iron Man?
Or not.
But wow… Check out these stunning metal sculptures of microbes by Erick James. Currently on display at the Beaty Biodiversity Museum at the University of British Columbia, Vancouver (Until January 5th).
Trichonympha
Trichomitopsis
Didinium
Dinoflagellate
Euglena
By Erick James. Via Beaty Biodiversity Museum
September 11, 2013
August 21, 2013
This is cool. Pyrocystis fusiformis night light in the shape of a dinosaur.
Interesting Kickstarter campaign by Yonder Biology. More info here.
June 17, 2013
Cell as a Death Star like entity (with mini virus spaceship in the mix). Awesome science illustration by Glen McBeth
* I wonder if he’s illustrated a card game before… (We do have a Darwin themed deck to work on)
By Glen McBeth (also check out his awesome blog).
May 15, 2013
Science things that are awesome…
(Also, all of these goofy pics are now being archived at a tumblr I just set up – scienceisawesomethatisall.tumblr.com)
O.K. Yesterday was our provincial elections (in British Columbia), and in the end, the Liberal party came out winning. There’s quite a few environmental issues that are in the forefront in my neck of the woods, not the least of which concerns the Northern Gateway pipeline.
The Liberals didn’t actually have the greatest platform on this (at least from an environmental or science policy standpoint), but here’s hoping the public continues to pressure them to do the “best” (re: what scientific expert peer review suggests) thing for the province, and indeed the planet at large.
Last Saturday, my lab opened up the entire ground floor of the Michael Smith Building to the public. This was in conjunction with Science Rendezvous, a cross Canada science festival, and in the case of UBC, organized by the Faculty of Science. In the house (so to speak) were folks from the Beaty Museum, Civil Engineering, Pathology, Physics and Astronomy, as well as the Engineering Physics Robotics lab (who also brought in their 3D printers). We also used the building as ground zero for a number of tours throughout campus.
All in all, a great day (and busy too!). In my space, I actually brought out about a dozen or dissecting scopes and collected a nice jar of pond scum. Kids (and their parents), with some basic instructions, were let loose to find whatever they could find in the pond water. Lots of cooties were found, protozoa and algae abound, but my favourite was this Hydra that I managed to get a decent picture of on my iPhone.
The scientific method – it’s not perfect, but it’s pretty much the best way out there on collecting your thoughts and information to make sound decisions. All the more so, if the decision is high stakes IMHO.
May 15, 2013
Alright, how much fun would a course called “Felt Microbiology 101” be?
Especially, if you get to play with creations like the below (a giant euglena, giant amoeba, and giant daphnia)
By Hiné Mizushima, via Thinx
March 4, 2013
Turns out the petri plate makes for a very nice canvas.
Not technically microbial art (which would have been very very impressive), but still pretty cool nevertheless…
By Klari Reis, via NotCot.org